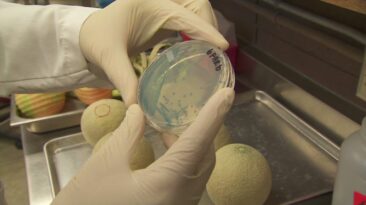

By Abbie Boudreau and Scott Bronstein, CNN Special Investigations Unit Island residents sue U.S., saying military made them sick – CNN.comNearly 40 years ago...
Layout B (with infinite scroll)
By Drew Griffin and Scott Bronstein, CNN Special Investigations
Read Morewww.cnn.com
By Scott Bronstein and Drew Griffin, CNN Special Investigations Unit
Read Morecnn.com
By Scott Bronstein and Drew Griffin, CNN Special Investigations Unit
Read Morewww.cnn.com
By Scott Bronstein and Drew Griffin, CNN Special Investigations Unit
Read Morewww.cnn.com